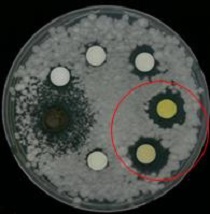

|
±âÈÄ¿¡³ÊÁöȯ°æºÎ »êÇÏ ±¹¸³³«µ¿°»ý¹°ÀÚ¿ø°ü(°üÀå ¿ë¼®¿ø)Àº ÃÖ±Ù ¾È¾çõ µî ¿ì¸®³ª¶ó ´ã¼ö ȯ°æ¿¡¼ ‘°úÀÏ °õÆÎÀ̺´(°ú¼ö źÀúº´)’ÀÇ ¾ïÁ¦ È¿´ÉÀ» Áö´Ñ ´ã¼ö¹Ì»ý¹° ±ÕÁÖ¿Í ½Å±Ô Ç×±Õ¹°ÁúÀ» ã¾Ò´Ù°í ¹àÇû´Ù.
±¹¸³³«µ¿°»ý¹°ÀÚ¿ø°ü ¿¬±¸ÁøÀº 2021³âºÎÅÍ ‘´ã¼ö±Õ·ù À¯·¡ ¹ÙÀÌ¿À ÀÛ¹°º¸È£Á¦¿ë ¿øÃµ¼ÒÀç ¹ß±¼’ ¿¬±¸°úÁ¦¸¦ ¼öÇàÇϸç, À¯¿ë ´ã¼ö±Õ·ù¸¦ È®º¸Çϰí À̸¦ Ȱ¿ëÇÑ ÀÛ¹°º¸È£Á¦ °³¹ß ¿¬±¸¸¦ Áö¼ÓÀûÀ¸·Î ÃßÁøÇϰí ÀÖ´Ù.
| |
 |
|
| ¡ã ´ã¼ö¹Ì»ý¹°ÀÇ °ú¼öźÀúº´¿¡ ´ëÇÑ Ç×±ÕÈ¿°ú. °ú¼ö źÀúº´±ÕÀÎ Colletotrichum ¼Ó °õÆÎÀÌ C. gloeosporioides (Cg), C. acutatum (Ca), C. siamense (Csi), C. fructicola (Cfr) µî 4Á¾. ½ºÆ®·¾Å丶À̼¼½º Ä«´ÏÆÛ·ç½º(S. caniferus)¿Í ¾Æ½ºÆÛÁú·¯½º Ç÷ÎÄÚ¼ö½º(A. floccosus) ±ÕÁÖ´Â 70~85%ÀÇ ±Õ»ç »ýÀå¾ïÁ¦À²À» ³ªÅ¸³Â´Ù. |
ÀÌ °úÁ¤¿¡¼ ¿¬±¸ÁøÀº °ú¼ö źÀúº´±Õ(Colletotrichum sp.)¿¡ ´ëÇØ Ç×±Õ È¿°ú¸¦ ³ªÅ¸³»´Â ±ÕÁÖ 2Á¾(¾Æ½ºÆÛÁú·¯½º Ç÷ÎÄÚ¼ö½º(Aspergillus floccosus), ½ºÆ®·¾Å丶À̼¼½º Ä«´ÏÆÛ·ç½º(Streptomyces caniferus)À» ¹ß°ßÇß´Ù. µÎ ±ÕÁÖ´Â °ú¼ö źÀúº´±ÕÀÇ ±Õ»ç»ýÀåÀ» 70% ÀÌ»ó ¾ïÁ¦ÇÏ´Â °ÍÀ¸·Î ³ªÅ¸³µ´Ù.
¾Æ¿ï·¯, µ¿ÀÏÇÑ ±ÕÁÖ¸¦ °íÃßÀÇ ¸ðÁ¾¿¡ ó¸®ÇßÀ» ¶§ ÁÙ±âÀÇ ±æÀÌ¿Í ±½±â°¡ ¾à 30% Áõ°¡ÇÏ´Â µî »ýÀ°ÀÌ ¶Ñ·ÇÇÏ°Ô Çâ»óµÇ´Â °á°ú°¡ È®ÀÎµÇ¾î ½Ä¹°»ýÀå ÃËÁø´É·Âµµ ÀÔÁõµÇ¾ú´Ù.
| |
 |
|
| ¡ã ´ã¼ö¹Ì»ý¹°ÀÇ °íÃß¿¡ ´ëÇÑ »ýÀ°ÃËÁøÈ¿°ú . ¾Æ½ºÆÛÁú·¯½º Ç÷ÎÄÚ¼ö½º(A. floccosus)¿Í ½ºÆ®·¾Å丶À̼¼½º Ä«´ÏÆÛ·ç½º(S. caniferus) ±ÕÁÖ´Â °íÃß À¯¹¦ÀÇ ÃÊÀå°ú ±½±âÀÇ »ýÀåÀ» ¾à 30%Á¤µµ Áõ´ë½ÃŰ´Â È¿°ú¸¦ º¸¿´´Ù. |
ÇØ´ç ¿¬±¸ °á°ú´Â ÀÌ´Þ(10¿ù) ¾ÈÀ¸·Î ƯÇã°¡ Ãâ¿øµÉ ¿¹Á¤ÀÌ´Ù.
¶ÇÇÑ ±¹¸³³«µ¿°»ý¹°ÀÚ¿ø°ü ¿¬±¸ÁøÀº 2019³â 3¿ù¿¡ °°Àº ¾È¾çõ¿¡¼ ¹ß°ßÇÑ ¿¡µå´Ï¾Æ(Edenia sp.) ±ÕÁÖ¿¡¼µµ °ú¼ö źÀúº´ º´¿ø±Õ¿¡ ´ëÇÑ Ç×±ÕÈ¿°ú¸¦ È®ÀÎÇß´Ù.
| |
|
|
| ¡ã ¿¡µå´Ï¾Æ ¼Ó(Edenia sp. NNIBRFG15114) À¯·¡ ¹°ÁúÀÇ Ç×±ÕÈ¿°ú. ½Å±Ô Ç×±Õ¹°Áú(10 mg/ml)Àº °ú¼öźÀúº´ º´¿ø±Õ¿¡ ´ëÇÑ Ç×Áø±Õ È¿°ú¸¦ º¸¿´´Ù. |
¿¬±¸ÁøÀº ÈÄ¼Ó ¿¬±¸¸¦ ÅëÇØ ¿¡µå´Ï¾Æ ±ÕÁÖ°¡ »ý»êÇÏ´Â »õ·Î¿î ±¸Á¶ÀÇ ÆéŸÀ̵å°è Ç×±Õ¹°Áú 2°¡Áö¸¦ ¹ß°ßÇß°í, ÇöÀç À̸¦ Ȱ¿ëÇÑ °ú¼ö źÀúº´ ¹æÁ¦¿ë ģȯ°æ ÀÛ¹°º¸È£Á¦ ½ÇÁõ ¿¬±¸¸¦ ÁøÇàÇϰí ÀÖ´Ù.
±èÀÇÁø ±¹¸³³«µ¿°»ý¹°ÀÚ¿ø°ü »ý¹°ÀÚ¿ø¿¬±¸½ÇÀåÀº “±¹³» ´ã¼öȯ°æ¿¡¼ ¹ß°ßÇÑ »ý¹°ÀÚ¿øÀ¸·ÎºÎÅÍ °ú¼ö źÀúº´ ¹æÁ¦¿¡ Ȱ¿ë °¡´ÉÇÑ »õ·Î¿î ¼ÒÀ縦 È®º¸ÇÑ µ¥ Å« Àǹ̰¡ ÀÖ´Ù”¶ó¸ç, “¾ÕÀ¸·Îµµ ´ã¼ö»ý¹°ÀÚ¿øÀÇ ½Ç¿ëȸ¦ À§ÇÑ ¿¬±¸¸¦ Àû±Ø ÃßÁøÇØ ³ª°¡°Ú´Ù”¶ó°í ¹àÇû´Ù.
< ÀúÀÛ±ÇÀÚ © ȯ°æ¹ý·ü½Å¹® ¹«´ÜÀüÀç ¹× Àç¹èÆ÷±ÝÁö > |